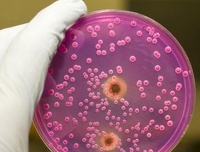

Другие названия и синонимы
Candidiasis.
МКБ-10 коды
- МКБ-10
- B37 Кандидоз
|
|
Описание
Кандидоз. Грибковое заболевание, преимущественно поражающее кожу и слизистые оболочки, реже внутренние органы. Различают кандидоз дыхательной, пищеварительной, мочеполовой систем. При резком ослаблении иммунитета может развиваться генерализованный кандидоз (кандидозный сепсис). Мочеполовой кандидоз у мужчин проявляется воспалением полового члена (покраснение, отечность, покрытие сероватым налетом и эрозиями, зуд, жжение и боль в области головки пениса). Возможны кандидозный уретрит и цистит. У женщин возникает поражение наружных половых органов и влагалища. Без своевременного лечения кандидоз принимает хроническое рецидивирующее течение.
Дополнительные факты
Кандидоз. Грибковое заболевание, преимущественно поражающее кожу и слизистые оболочки, реже внутренние органы. Различают кандидоз дыхательной, пищеварительной, мочеполовой систем. При резком ослаблении иммунитета может развиваться генерализованный кандидоз (кандидозный сепсис). Мочеполовой кандидоз у мужчин проявляется воспалением полового члена (покраснение, отечность, покрытие сероватым налетом и эрозиями, зуд, жжение и боль в области головки пениса). Возможны кандидозный уретрит и цистит. У женщин возникает поражение наружных половых органов и влагалища. Без своевременного лечения кандидоз принимает хроническое рецидивирующее течение.
Урогенитальный кандидоз вызывается дрожжеподобными грибками рода Кандида (Candida), представителями нормальной микрофлоры слизистых оболочек половых органов. Развитие кандидоза происходит в результате интенсивного размножения грибков Кандида и нарушения ими естественного баланса среды мочеполового тракта. Развитию кандидоза в немалой степени способствует общее снижение сопротивляемости организма.
Мочеполовой кандидоз не является угрожающим здоровью и жизни заболеванием, однако он крайне неприятен своими проявлениями, приводящими к нарушениям в интимной и психо-эмоциональной сферах. Кроме того, наличие кандидоза может говорить о тяжелой сопутствующей патологии (сахарном диабете, ВИЧ-инфекции и тд ).
Кандидоз половых органов или, так называемая, молочница, поражает слизистые оболочки урогенитального тракта мужчин и женщин, являясь по своей сути половой инфекцией.
Нередко молочнице сопутствуют и другие заболевания с половым путем передачи: хламидиоз, гонорея, трихомоноз и тд.
Острое и подострое течение кандидоза длится не более 2 месяцев. В этот период ярко выражены отек, гиперемия, выделения из половых путей и другие воспалительные симптомы. Хронические формы кандидоза характеризуются давностью течения свыше 2 месяцев. На слизистых оболочках развиваются очаги сухости, гиперпигментации, инфильтрации, атрофии тканей.
В последнее время нередкими стали атипичные, стертые и устойчивые к проводимому лечению формы мочеполового кандидоза.
• прием антибактериальных и ряда гормональных лекарственных препаратов;
• беременность;
• кандидоз (дисбактериоз) кишечника;
• сахарный диабет;
• ВИЧ и другие инфекции, подавляющие иммунную систему;
• излишнее спринцевание;
• ношение синтетического и тесного белья;
• длительное неблагоприятное воздействие физических факторов (работа в теплых влажных помещениях и тд ).
Урогенитальный кандидоз вызывается дрожжеподобными грибками рода Кандида (Candida), представителями нормальной микрофлоры слизистых оболочек половых органов. Развитие кандидоза происходит в результате интенсивного размножения грибков Кандида и нарушения ими естественного баланса среды мочеполового тракта. Развитию кандидоза в немалой степени способствует общее снижение сопротивляемости организма.
Мочеполовой кандидоз не является угрожающим здоровью и жизни заболеванием, однако он крайне неприятен своими проявлениями, приводящими к нарушениям в интимной и психо-эмоциональной сферах. Кроме того, наличие кандидоза может говорить о тяжелой сопутствующей патологии (сахарном диабете, ВИЧ-инфекции и тд ).
Кандидоз половых органов или, так называемая, молочница, поражает слизистые оболочки урогенитального тракта мужчин и женщин, являясь по своей сути половой инфекцией.
Нередко молочнице сопутствуют и другие заболевания с половым путем передачи: хламидиоз, гонорея, трихомоноз и тд.
Острое и подострое течение кандидоза длится не более 2 месяцев. В этот период ярко выражены отек, гиперемия, выделения из половых путей и другие воспалительные симптомы. Хронические формы кандидоза характеризуются давностью течения свыше 2 месяцев. На слизистых оболочках развиваются очаги сухости, гиперпигментации, инфильтрации, атрофии тканей.
В последнее время нередкими стали атипичные, стертые и устойчивые к проводимому лечению формы мочеполового кандидоза.
Развитие кандидоза половых органов.
По данным проведенных в области венерологии исследований наиболее часто развитию кандидоза половых органов способствуют следующие факторы:• прием антибактериальных и ряда гормональных лекарственных препаратов;
• беременность;
• кандидоз (дисбактериоз) кишечника;
• сахарный диабет;
• ВИЧ и другие инфекции, подавляющие иммунную систему;
• излишнее спринцевание;
• ношение синтетического и тесного белья;
• длительное неблагоприятное воздействие физических факторов (работа в теплых влажных помещениях и тд ).
Генерализованная форма кандидоза.
В особо неблагоприятных случаях патологический процесс может захватывать многие органы с развитием генерализованной формы кандидоза. Факторами риска в развитии генерализации кандидоза служат недоношенность, применение глюкокортикоидов и антибиотиков, искусственное питание, химиотерапия, наркомания, хирургические операции и послеоперационный период и тд Генерализованный кандидоз протекает с выраженной лихорадкой, реакциями со стороны центральной нервной системы, нарушениями функций желудочно-кишечного тракта, изменениями показателей периферической крови (лейкоцитозом, нейтрофилезом со сдвигом влево), нарушениями гомеостаза.Клиническая картина
Мочеполовой кандидоз больше распространен среди женщин. Порядка 75% женщин хоть раз в жизни сталкивались с проявлениями вульвовагинального кандидоза, и у половины из них болезнь носила рецидивирующий характер.
У женщин кандидоз мочеполового тракта характеризуется поражением слизистых вульвы и влагалища, реже - шейки матки, уретры и мочевого пузыря.
Кандидозный вульвит и вульвовагинит, не затрагивающий мочевыводящие пути, имеют следующие проявления:
• обильные, молочно-белого цвета и творожистой консистенции выделения из влагалища с неприятным запахом;
• ощущение раздражения, зуда или жжения или в области вульвы, усиливающееся после мочеиспускания, во время сна или после принятия ванны;
• болезненность половых сношений, усиление симптомов раздражения и характерного неприятного запах после полового акта.
При кандидозном вульвите происходит поражение дрожжеподобными грибками области наружных половых органов: клитора, малых и больших половых губ, преддверия влагалища. Кандидоз вульвы может протекать в типичных и атипичных клинических формах:
К типичным формам кандидоза вульвы относятся:
• катарально-мембранозный вульвит острого и подострого течения;
• катаральный хронический вульвит.
Среди атипичных форм кандидоза вульвы выделяют:
• лейкоплакиевидный хронический вульвит;
• краурозоподобный хронический вульвит;
• асимптомный пруригинозный хронический вульвит;
Также нередко встречаются смешанные варианты острой грибковой инфекции: кандидозно - бактериальные, кандидозно - хламидийные, кандидозно - гонорейные, кандидозно - трихомонадные вульвиты.
Течение типичных форм кандидоза вульвы характеризуется жжением и зудом, интенсивность которых усиливается перед менструацией и уменьшается или исчезает в менструальный и постменструальный периоды.
Пораженные кандидозом слизистые оболочки вульвы гиперемированы, имеют багрово-синюшный оттенок. На слизистых видны мелко-точечные пузырьки, которые при вскрытии образуются обширные эрозии. Малые половые губы покрыты наслоениями в виде белых творожистых пленок.
В хронической форме кандидоза вульвы отмечается застойная гиперемия и инфильтрация тканей, их утолщение и повышенная сухость.
Атипичное течение кандидоза вульвы встречается редко и протекает в хронической форме.
Со слизистых оболочек вульвы кандидоз может распространяться на пахово-бедренные складки и перианальную область. Такие проявления обычно наблюдаются при хроническом кандидозе у больных с микседемой, сахарным диабетом, гипофункцией яичников.
Для кандидозного вагинита характерно распространение грибкового поражения на слизистые оболочки влагалища и нередко влагалищную часть шейки матки.
Кандидоз влагалища протекает в четырех основных формах:
• кандидозный катарально-экссудативно-мембранозный вагинит острого и подострого течения;
• смешанный кандидозно-бактериальный катарально-экссудативный вагинит острого и подострого течения;
• кандидозный катаральный подострый и хронический вагинит;
• асимптомный кандидозный хронический вагинит.
При кандидозе влагалища слизистые оболочки ярко гиперемированы, покрыты сметанообразным или рыхлым крошковатым налетом. Стенки и своды влагалища, а также влагалищная часть шейки матки эрозированы. Выделения обильные, творожистой или сливкообразной консистенции, иногда пенистого и даже гнойного характера с неприятным запахом. Субъективно пациентки отмечают умеренную болезненность, жжение и зуд во влагалище.
Кандидозный эндоцервицит не встречается самостоятельно, а развивается только в связи с влагалищным кандидозом.
В результате кандидоза влагалища грибковая инфекция восходящим путем проникает через наружный зев в канал шейки матки. Часто причиной развития кандидозного эндоцервицита служит неполноценная функция яичников. При типичном течении кандидоза шейки матки из цервикального канала выделяются белые крошковатые комочки или белая густая слизь. Снаружи поверхность шейки матки покрыта белесоватыми пленками. Стертая форма кандидоза шейки матки характеризуется скудным молочно-слизистым отделяемым.
Сравнительно редкими проявлениями мочеполового кандидоза у женщин являются кандидозные уретрит и цистит. Острый кандидозный уретрит характеризуется постоянными тупыми болями в нижней части живота и дизурическими расстройствами: резями, жжением, учащенными и болезненными позывами к мочеиспусканию. При осмотре отмечается отечность и гиперемия губок уретры, творожистые комочки у наружного отверстия мочеиспускательного канала.
Острый цистит при кандидозе проявляется болезненностью при мочеиспускании и частыми ложными позывами.
Хронические кандидозные уретрит и цистит вне обострений протекают со стертой симптоматикой либо без нее.
Мочеполовой кандидоз у мужчин чаще проявляется в форме баланита - воспаления головки полового члена или постита - воспаления внутреннего листка крайней плоти, или в их сочетании.
Кандидозный баланопостит относится к инфекциям, передаваемым половым путем. Его рост связан с распространенностью мочеполового кандидоза у женщин в связи с применением гормональных контрацептивов, антибактериальных и противотрихомонадных средств.
Клиническая картина кандидозного баланопостита зависит от формы его течения: мембранозной, эрозивной или эритемно-пустулезной. Субъективно обычно отмечается зуд и жжение головки полового члена. Кожа в области головки пениса, венечной борозды, а также внутренний листок крайней плоти гиперемированы, отечны и воспалены, покрыты белесо-сероватым налетом. Инфильтрация крайней плоти затрудняет обнажение головки. Головка полового члена может эрозироваться и мокнуть, что облегчает присоединение вторичной гнойной инфекции. При кандидозном баланопостите симптомы расстройства мочеиспускания отсутствуют.
Хроническое течение кандидозного баланопостита может осложниться фимозом из-за постепенного рубцового сужения крайней плоти. Среди других осложнений кандидозного баланопостита встречаются лимфаденит, лимфангит, рожистое воспаление полового члена, кандидагранулемы, бородавчатые разрастания, карцинома полового члена.
Уретра при кандидозе у мужчин поражается реже, и обычно кандидозный уретрит протекает в подострой форме. Инкубационный период составляет от 2 недель до 2 месяцев. Кандидоз уретры сопровождается легким зудом и чувством жжения, обычно скудными, слизисто-водянистыми, реже - обильными и гнойными выделениями из уретры. При уретроскопическом исследовании отмечается белесоватый налет в виде на слизистой оболочке мочеиспускательного канала. Снятие налета сопровождается обнажением отечной и резко гиперемированной слизистой оболочки уретры.
Осложнениями кандидоза уретры часто служат простатит, цистит, эпидидимит.
Ассоциированные симптомы: Белые выделения из влагалища. Боль в гениталиях у женщин. Боль в половом члене. Боль в уретре. Боль во влагалище. Выделения из влагалища (бели). Зуд в интимной зоне у женщин. Зуд в интимной зоне у мужчин. Зуд во влагалище. Зуд вульвы. Зуд полового члена. Лейкоцитоз. Нейтрофилез. Рези при мочеиспускании у мужчин. Увеличение СОЭ. Учащенное мочеиспускание.
У женщин кандидоз мочеполового тракта характеризуется поражением слизистых вульвы и влагалища, реже - шейки матки, уретры и мочевого пузыря.
Кандидозный вульвит и вульвовагинит, не затрагивающий мочевыводящие пути, имеют следующие проявления:
• обильные, молочно-белого цвета и творожистой консистенции выделения из влагалища с неприятным запахом;
• ощущение раздражения, зуда или жжения или в области вульвы, усиливающееся после мочеиспускания, во время сна или после принятия ванны;
• болезненность половых сношений, усиление симптомов раздражения и характерного неприятного запах после полового акта.
При кандидозном вульвите происходит поражение дрожжеподобными грибками области наружных половых органов: клитора, малых и больших половых губ, преддверия влагалища. Кандидоз вульвы может протекать в типичных и атипичных клинических формах:
К типичным формам кандидоза вульвы относятся:
• катарально-мембранозный вульвит острого и подострого течения;
• катаральный хронический вульвит.
Среди атипичных форм кандидоза вульвы выделяют:
• лейкоплакиевидный хронический вульвит;
• краурозоподобный хронический вульвит;
• асимптомный пруригинозный хронический вульвит;
Также нередко встречаются смешанные варианты острой грибковой инфекции: кандидозно - бактериальные, кандидозно - хламидийные, кандидозно - гонорейные, кандидозно - трихомонадные вульвиты.
Течение типичных форм кандидоза вульвы характеризуется жжением и зудом, интенсивность которых усиливается перед менструацией и уменьшается или исчезает в менструальный и постменструальный периоды.
Пораженные кандидозом слизистые оболочки вульвы гиперемированы, имеют багрово-синюшный оттенок. На слизистых видны мелко-точечные пузырьки, которые при вскрытии образуются обширные эрозии. Малые половые губы покрыты наслоениями в виде белых творожистых пленок.
В хронической форме кандидоза вульвы отмечается застойная гиперемия и инфильтрация тканей, их утолщение и повышенная сухость.
Атипичное течение кандидоза вульвы встречается редко и протекает в хронической форме.
Со слизистых оболочек вульвы кандидоз может распространяться на пахово-бедренные складки и перианальную область. Такие проявления обычно наблюдаются при хроническом кандидозе у больных с микседемой, сахарным диабетом, гипофункцией яичников.
Для кандидозного вагинита характерно распространение грибкового поражения на слизистые оболочки влагалища и нередко влагалищную часть шейки матки.
Кандидоз влагалища протекает в четырех основных формах:
• кандидозный катарально-экссудативно-мембранозный вагинит острого и подострого течения;
• смешанный кандидозно-бактериальный катарально-экссудативный вагинит острого и подострого течения;
• кандидозный катаральный подострый и хронический вагинит;
• асимптомный кандидозный хронический вагинит.
При кандидозе влагалища слизистые оболочки ярко гиперемированы, покрыты сметанообразным или рыхлым крошковатым налетом. Стенки и своды влагалища, а также влагалищная часть шейки матки эрозированы. Выделения обильные, творожистой или сливкообразной консистенции, иногда пенистого и даже гнойного характера с неприятным запахом. Субъективно пациентки отмечают умеренную болезненность, жжение и зуд во влагалище.
Кандидозный эндоцервицит не встречается самостоятельно, а развивается только в связи с влагалищным кандидозом.
В результате кандидоза влагалища грибковая инфекция восходящим путем проникает через наружный зев в канал шейки матки. Часто причиной развития кандидозного эндоцервицита служит неполноценная функция яичников. При типичном течении кандидоза шейки матки из цервикального канала выделяются белые крошковатые комочки или белая густая слизь. Снаружи поверхность шейки матки покрыта белесоватыми пленками. Стертая форма кандидоза шейки матки характеризуется скудным молочно-слизистым отделяемым.
Сравнительно редкими проявлениями мочеполового кандидоза у женщин являются кандидозные уретрит и цистит. Острый кандидозный уретрит характеризуется постоянными тупыми болями в нижней части живота и дизурическими расстройствами: резями, жжением, учащенными и болезненными позывами к мочеиспусканию. При осмотре отмечается отечность и гиперемия губок уретры, творожистые комочки у наружного отверстия мочеиспускательного канала.
Острый цистит при кандидозе проявляется болезненностью при мочеиспускании и частыми ложными позывами.
Хронические кандидозные уретрит и цистит вне обострений протекают со стертой симптоматикой либо без нее.
Мочеполовой кандидоз у мужчин чаще проявляется в форме баланита - воспаления головки полового члена или постита - воспаления внутреннего листка крайней плоти, или в их сочетании.
Кандидозный баланопостит относится к инфекциям, передаваемым половым путем. Его рост связан с распространенностью мочеполового кандидоза у женщин в связи с применением гормональных контрацептивов, антибактериальных и противотрихомонадных средств.
Клиническая картина кандидозного баланопостита зависит от формы его течения: мембранозной, эрозивной или эритемно-пустулезной. Субъективно обычно отмечается зуд и жжение головки полового члена. Кожа в области головки пениса, венечной борозды, а также внутренний листок крайней плоти гиперемированы, отечны и воспалены, покрыты белесо-сероватым налетом. Инфильтрация крайней плоти затрудняет обнажение головки. Головка полового члена может эрозироваться и мокнуть, что облегчает присоединение вторичной гнойной инфекции. При кандидозном баланопостите симптомы расстройства мочеиспускания отсутствуют.
Хроническое течение кандидозного баланопостита может осложниться фимозом из-за постепенного рубцового сужения крайней плоти. Среди других осложнений кандидозного баланопостита встречаются лимфаденит, лимфангит, рожистое воспаление полового члена, кандидагранулемы, бородавчатые разрастания, карцинома полового члена.
Уретра при кандидозе у мужчин поражается реже, и обычно кандидозный уретрит протекает в подострой форме. Инкубационный период составляет от 2 недель до 2 месяцев. Кандидоз уретры сопровождается легким зудом и чувством жжения, обычно скудными, слизисто-водянистыми, реже - обильными и гнойными выделениями из уретры. При уретроскопическом исследовании отмечается белесоватый налет в виде на слизистой оболочке мочеиспускательного канала. Снятие налета сопровождается обнажением отечной и резко гиперемированной слизистой оболочки уретры.
Осложнениями кандидоза уретры часто служат простатит, цистит, эпидидимит.
Ассоциированные симптомы: Белые выделения из влагалища. Боль в гениталиях у женщин. Боль в половом члене. Боль в уретре. Боль во влагалище. Выделения из влагалища (бели). Зуд в интимной зоне у женщин. Зуд в интимной зоне у мужчин. Зуд во влагалище. Зуд вульвы. Зуд полового члена. Лейкоцитоз. Нейтрофилез. Рези при мочеиспускании у мужчин. Увеличение СОЭ. Учащенное мочеиспускание.
|
|
Диагностика
При возникновении симптомов кандидоза мужчины обычно обращаются за помощью к урологу, а женщины приходят на консультацию гинеколога. Диагностику мочеполового кандидоза осуществляют на основе жалоб и осмотра слизистых оболочек половых органов. Диагноз кандидоза подтверждается исследованием отделяемого влагалища или пениса методом световой микроскопии, бакпосевом и определением чувствительности выделенных разновидностей сandida к противогрибковым препаратам.
Консультация венеролога необходима для поведения дифференциальной диагностики кандидоза с трихомониазом, гонореей, гарднереллезом, другими урогенитальными инфекциями и исключения сопутствующих ИППП.
При кандидозе половых органов необходимо исключить наличие хронических заболеваний организма, провести оценку состояния иммунитета.
Для диагностики кандидоза не требуется использования высокоточных лабораторных методик, таких, как ПИФ или ПЦР, выявляющих даже единичных возбудителей. Критерием постановки диагноза при кандидозе мочеполовых органов служит выявление факта интенсивного размножения грибковых возбудителей.
Консультация венеролога необходима для поведения дифференциальной диагностики кандидоза с трихомониазом, гонореей, гарднереллезом, другими урогенитальными инфекциями и исключения сопутствующих ИППП.
При кандидозе половых органов необходимо исключить наличие хронических заболеваний организма, провести оценку состояния иммунитета.
Для диагностики кандидоза не требуется использования высокоточных лабораторных методик, таких, как ПИФ или ПЦР, выявляющих даже единичных возбудителей. Критерием постановки диагноза при кандидозе мочеполовых органов служит выявление факта интенсивного размножения грибковых возбудителей.
Лечение
Для лечения мочеполового кандидоза проводят мероприятия как местного, так и общего характера. Выбор метода терапии определяется тяжестью течения кандидоза. Легкие формы кандидоза половых органов обычно лечатся с применением местных препаратов, тогда как тяжелые формы предполагают дополнительное использование препаратов общего действия.
Местная терапия кандидоза проводится вагинальными свечами и таблетками, мазями, содержащими противогрибковые препараты: нистатин, клотримазол, пимафуцин, миконазол, кетоконазол.
Препараты общего действия для лечения кандидоза принимаются внутрь. С этой целью назначаются флуконазол, итраконазол.
Побочным действиям большинства из названных препаратов для лечения кандидоза является подавление нормальной микрофлоры половых органов, особенно лактобацилл, в норме исключающих рост патогенных микроорганизмов. Для восстановления нормального баланса микрофлоры половых органов, после курса противогрибковой терапии кандидоза назначаются эубиотики, включающие лактобактерии, или инъекции препарата, содержащего инактивированные варианты лактобацилл.
Поскольку кандидоз поражает не только половые органы, но и кишечник, в его лечении применяются витамины группы В, синтез которых нарушается при дисбактериозе кишечника. Также оправдано при кандидозе назначение поливитаминов.
Одновременное лечение мочеполового кандидоза проводится всем половым партнерам пациента.
Местная терапия кандидоза проводится вагинальными свечами и таблетками, мазями, содержащими противогрибковые препараты: нистатин, клотримазол, пимафуцин, миконазол, кетоконазол.
Препараты общего действия для лечения кандидоза принимаются внутрь. С этой целью назначаются флуконазол, итраконазол.
Побочным действиям большинства из названных препаратов для лечения кандидоза является подавление нормальной микрофлоры половых органов, особенно лактобацилл, в норме исключающих рост патогенных микроорганизмов. Для восстановления нормального баланса микрофлоры половых органов, после курса противогрибковой терапии кандидоза назначаются эубиотики, включающие лактобактерии, или инъекции препарата, содержащего инактивированные варианты лактобацилл.
Поскольку кандидоз поражает не только половые органы, но и кишечник, в его лечении применяются витамины группы В, синтез которых нарушается при дисбактериозе кишечника. Также оправдано при кандидозе назначение поливитаминов.
Одновременное лечение мочеполового кандидоза проводится всем половым партнерам пациента.